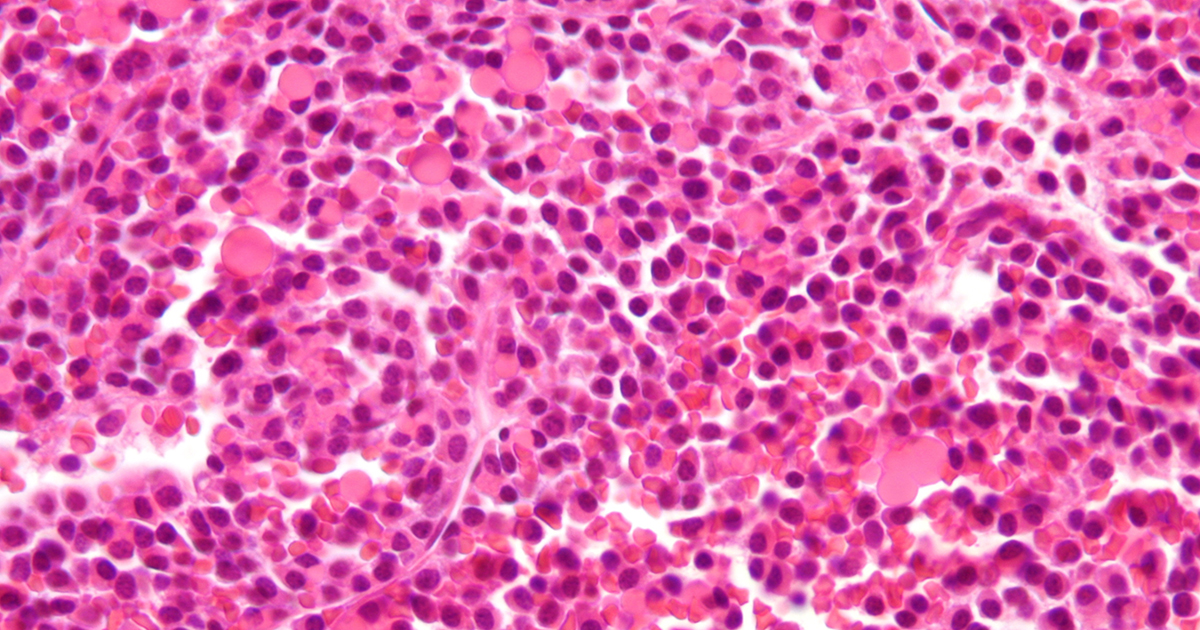

Dr. Cristiana Ciortea, medic primar Radiologie Imagistică Medicală la Spitalul Județean de Urgență Cluj-Napoca, a explicat la Doctor online care sunt vârstele…
La ce vârstă ar trebui făcut primul control ortopedic la copii și de ce este această investigație importantă? Află și…
Din totalul cancerelor sângelui, mielomul multiplu reprezintă 10-15% dintre acestea. Afectează în special persoane peste 60 de ani, bărbații mai…
Peste 100 de mame diagnosticate cu COVID-19 au născut la Cluj, într-un an, potrivit dr. Daniel Mureșan, de la Clinica…
Ce faci dacă ai suferit o fractură de orice fel, în această perioadă? Află de la prof. dr. Dan Cosma,…
Dr. Anamaria Șipoș, radioterapeut și dr. Andrei Ungureanu, oncolog, au vorbit la emisunea Doctor online, realizată pe Via Cluj TV…
În fiecare minut, în Europa, moare o persoană de cancer bronho-pulmonar, potrivit Organizației Mondiale a Sănătății. În lume, la fiecare…
Medicul specialist dermato-venerolog Florina Raica a vorbit în cadrul emisiunii “Doctor online”, la Via Cluj TV despre cum putem combate…
Periuță cu cap rotativ, periuță cu vibrații sonice sau chiar periuțe ionice? Pe care să o alegi? Care se potrivește…
Dacă nu ai fost înzestrat, în mod natural, cu un zâmbet perfect, cu dinți drepți, aliniați și estetici, te poți…